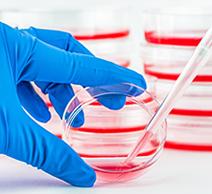

Na�ve Bacillus licheniformis Protease
Catalog Number NATE-0633
Descrip�on
A protease is an enzyme that helps proteolysis: protein catabolism by hydrolysis of pep�de bonds. The na�ve Bacillus licheniformis protease belongs to the serine endopep�dase sub�lisin family, which breaks the pep�de bond non-specifically under alkaline condi�ons. The enzyme is ac�ve in aqueous solu�ons and in some organic solvents such as dry octane. The protease is inac�vated by serine ac�ve-site inhibitors, such as phenylmethylsulfonyl fluoride (PMSF) and diisopropylfluorophosphate.
Product Informa�on
Catalog number: NATE-0633
EC number: 3.4.21.62
CAS number: 9001-92-7
Source: Bacillus licheniformis
Molecular Weight: 27 kDa
Form: Lyophilized powder
Ac�vity: >8 units/mg solid
Op�mum pH: 8-10
Applica�ons
Ac�ve temperature: 4-75 °C
Op�mum temperature: 55-60 °C
Specificity: Sub�lisin A is a member of the serine S8 endoproteinase family. It has broad specificity with a preference for a large uncharged residue in the P1 posi�on. It hydrolyzes na�ve and denatured proteins, and is ac�ve under alkaline condi�ons.
•The protease has a broad specificity towards na�ve and denatured proteins.
•The product has been used in �ssue dissocia�on and single cell isola�on from specimen during prepara�on for single-cell RNA sequencing at cold temperatures.

•It has been used in the process of isola�on of subsarcolemmal (SS) and intermyofibrillar (IMF) mitochondria that can be used for func�onal in vitro studies.
•The product has been used with other enzymes for in situ proteolysis to produce crystals suitable for structure determina�on.
Publica�ons
Na�ve Bacillus licheniformis protease can be used for single-cell dissocia�on at 4-8°C. The protocol involves mincing the specimen, diges�on with protease on ice, incuba�on with Miltenyi gentleMACS and tritura�on or physical disrup�on, followed by filtra�on. Reported examples can be found in the following published research ar�cles:
Title
Probabilis�c cell type assignment of single-cell transcriptomic data reveals spa�otemporal microenvironment dynamics in human cancers
Ulcera�ve coli�s mucosal transcriptomes reveal mitochondriopathy and personalized mechanisms underlying disease severity and treatment response
Psychrophilic proteases drama�cally reduce single-cell RNA-seq ar�facts: a molecular atlas of kidney development
